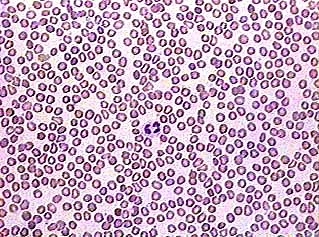
Blood Cells

-
Egyptians used bloodletting to try to cure diseases
-
Greeks distinguished between arteries and veins.
-
Anton Van Leeuwenhoek viewed blood cells under a microscope
-
First blood transfusion was performed
-
Karl Landsteiner discovered blood types A, B, O
-
Alfred Decastello discovered AB blood
-
Percy Oliver discovered the 1st donor service
-
Mayo Clinic developed a method to store blood for transfusions.
-
Dr. Bernard Fantus established the 1st blood bank
-
Karl Landsteiner discovered the Rh protein
-
The first case of AIDS recorded in the Congo
-
Robert Gallo identified the virus of AIDS
-
Development of ELISA test to screen fro diseases for HIV
-
Scientist began developing blood-screening tests for infectious diseases
Looking for a timeline maker?
Create timelines for projects, roadmaps, history, lessons, legal cases, and stories with Timetoast. Timetoast is a timeline maker for work, school, research, and stories.